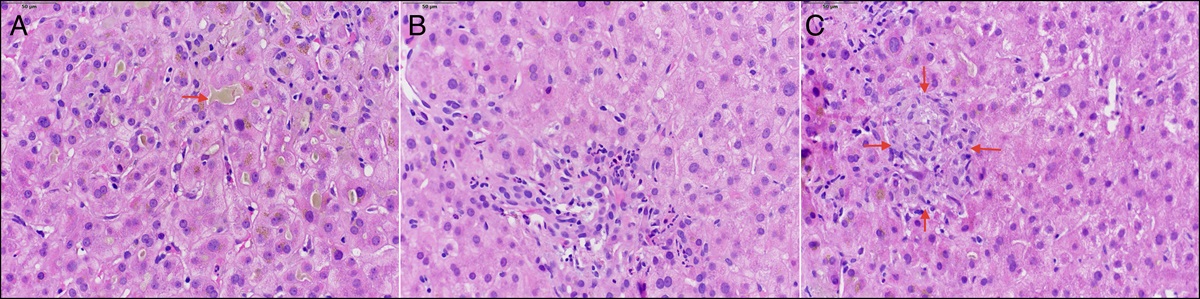
journals.lww.com

patricknotstar
Platinum
- Joined
- May 24, 2020
- Posts
- 1,235
- Reputation
- 1,814
great advice , lets see your physiqueyou can get this body in like two months of working out maybe even less JFL
just eat well and lose bodyfat
you want a beach body, summer is still like 6-7 months away
you can use this time to workout so you can mog in the summer